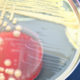

A key part of any chemistry lab, lab specialist Techmate offers a range of high-quality chromatographic instruments and accessories from trusted manufacturers such as Carl Roth.
In addition to a full range of chromatography glassware papers and replacement instrument parts, the company offers grades of silica gels, resins and Dowex to meet all requirements. Mainland UK orders are shipped for next day delivery, and the company offers free returns or exchanges within 30 days.
For more information about this range, please click here.